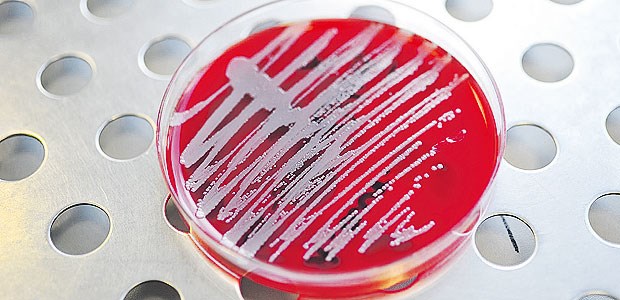

Kliniken
Resistente Erreger auf dem Vormarsch
Multiresistente Erreger werden in den Kliniken ein immer größeres Risiko. Ihr Anteil an allen gemessenen Keimen ist in den vergangenen fünf Jahren um bis zu 200 Prozent gestiegen.
Veröffentlicht:
Bakterienkultur: Keime werden in Kliniken immer häufiger zum Problem.
© Klaus Rose
BERLIN. Multiresistente Krankheitserreger kommen in den Krankenhäusern in Deutschland immer häufiger vor. In Hunderten Kliniken stieg ihr Anteil - gemessen an der Keimbelastung insgesamt - in den vergangenen Jahren deutlich an.
Das geht aus einer Liste aus dem Bundesgesundheitsministerium hervor, die der "Ärzte Zeitung" vorliegt. Sie stammt aus einer Antwort der Bundesregierung auf eine Anfrage der Grünen-Bundestagsfraktion.
Je nach Bakterien-Art stieg der Anteil an Keimen, die gegen alle Breitband-Antibiotika wenig oder ganz unempfindlich sind, an allen gemessenen Keimen in den letzten fünf Jahren um bis zu 200 Prozent. Diese Anteile bewegen sich je nach Erreger zwischen 0,04 und 17,9 Prozent.
Die aufgeführten Fallzahlen lagen 2012 etwa beim Erreger Escherichia coli bei 55. Zum Vergleich: Zwei Jahre zuvor waren es noch 16.
Bei Acinetobacter baumannii waren es im Jahr 2012 insgesamt 250, zwei Jahre zuvor 217, bei Pseudomonas aeruginosa bei 3888 nach 2722 zwei Jahre vorher.
"Die rapide Resistenzentwicklung ist ein weiterer Warnschuss"
Grundlage der Daten ist ein Kontrollprojekt zu Antibiotika-Resistenzen. In diesem Projekt teilen Kliniken ihre einschlägigen Daten mit.
Der Vergleich der absoluten Zahlen sei jedoch nicht zulässig, warnt die Gesundheitsstaatssekretärin Annette Widmann-Mauz. Der Grund: Die Zahl der teilnehmenden Häuser veränderte sich über die Jahre. Im Jahr 2010 waren es nur 269 Kliniken, 2012 waren es bereits 286.
Grünen-Politiker Friedrich Ostendorff warf den zuständigen Bundesministern Daniel Bahr (FDP) und Ilse Aigner (CSU) Versagen beim Kampf gegen Antibiotika-Resistenzen vor: "Die rapide Resistenzentwicklung ist ein weiterer Warnschuss."
Jeder Patient müsse vor Aufnahme in ein Krankenhaus auf gefährliche Keime hin untersucht werden, forderte er.
CDU-Politiker Jens Spahn verteidigte den Kurs der schwarz-gelben Koalition der letzten vier Jahre: "Meldepflichten wurden ausgeweitet, Schnelltests sind Standard in vielen Kliniken und wir finanzieren erstmals ausdrücklich die Aus- und Weiterbildung von Hygienefachkräften."
Zudem hätten die Bundesländer ihre Hygieneverordnungen verschärfen müssen. "Was wir noch verbessern müssen, ist die Erforschung von neuen Antibiotika", räumte Spahn ein.
Klinik-Patienten überwiegend gut versorgt
Einem neuen offiziellen Report des AQUA-Instituts zufolge werden Patienten in Krankenhäusern allerdings überwiegend gut behandelt und versorgt. Der Report liegt der "Ärzte Zeitung" vor.
"Nach Einschätzung der beim AQUA-Institut angesiedelten Expertengruppen, den Bundesfachgruppen, gab es im Jahr 2012 deutlich weniger Auffälligkeiten, bei denen über alle Krankenhäuser hinweg Handlungsbedarf gesehen wird, als im Jahr zuvor", sagte Robert Deg, Sprecher des Instituts. Das dürfe aber kein Freibrief sein, warnte er.
Bei der genauen Betrachtung stelle man fest, dass es Bereiche und Krankenhäuser gebe, in denen die Qualität nicht optimal sei und an deren Verbesserung gearbeitet werden müsse."
Aus Sicht des Hauptgeschäftsführer der Deutschen Krankenhausgesellschaft (DKG), Georg Baum, sollten die Erhebungen ausgedehnt werden. "Die Beurteilung der Qualität der Versorgung darf nicht mit der Entlassung an der Krankenhauspforte aufhören."
So solle der Erfolg von Therapien über längere Zeit hinweg besser verfolgt werden. (mit dpa)